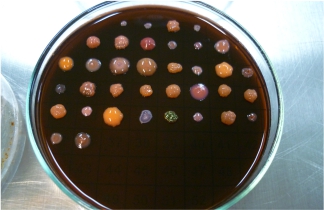
Contacto

Z7_NQ5E12C0LG7T90AU2AE73C0I13
Portal U de A - Cabezote - WCV(JSR 286)
Z7_NQ5E12C0LG7T90AU2AE73C0IH2
Index Signpost
Ecología Microbiana y Bioprospección
Z7_NQ5E12C0LG7T90AU2AE73C0IH1
UdeA - Rotador Interno (Home2) - WCV(JSR 286)
Z7_NQ5E12C0LG7T90AU2AE73C0I90
UdeA - Título de sección - WCV(JSR 286)
Conoce la UdeA
Z7_NQ5E12C0LG7T90AU2AE73C0I92
Portal U de A - Destacados Home 2 - WCV(JSR 286)
Z7_NQ5E12C0LG7T90AU2AE73C0I91
UdeA - Título de sección - WCV(JSR 286)
También te puede interesar
Z7_NQ5E12C0LG7T90AU2AE73C0I93
Listado Home 2
Z7_NQ5E12C0LG7T90AU2AE73C0IP0
Footer - Udea - JSR(286)
Z7_NQ5E12C0LG7T90AU2AE73C0IP2